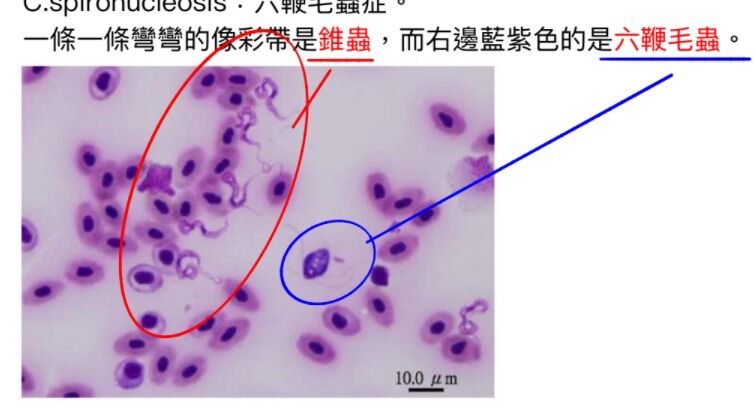
686a26acd7c66.jpg

70.下列何種鞭毛蟲可造成魚體全身性感染?
(A)Spironucleus salmonis
(B)Myxobolus cerebralis
(C)Piscinoodinium spp.
(D)Tetrahymena corlissi
答案:登入後查看
統計: A(878), B(537), C(339), D(327), E(0) #2743600
統計: A(878), B(537), C(339), D(327), E(0) #2743600
詳解 (共 3 筆)
#6523576
Hexamita 六鞭毛蟲 spironucleosis 六鞭毛蟲症
單細胞,其實有八根鞭毛,腸道常在菌,緊迫可引起大量複製+系統性感染
常寄生淡水或海水觀賞魚類,主寄生於腸道中,亦可於膽囊、腎臟、肝臟、血液及體表發現。
觀賞魚常見頭洞症,可以用Metronidazole(勿用於經濟魚類)
潛在性營養不良會誘發

4
0